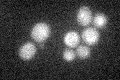
YNR072W
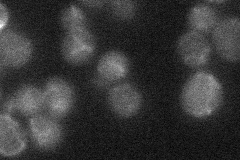
YNR072W
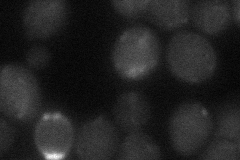
YNR072W

View description
Hexose transporter, up-regulated in media containing raffinose and galactose at pH 7.7 versus pH 4.7, repressed by high levels of glucose
Localization:
Intensity:
Fold change:
Significance:
-
C’ GFP library in SD
below threshold17.03 -
N' NOP1pr-GFP in SD

cell periphery,vacuole48.138 -
N' TEF2pr-mCherry in SD

cell periphery,vacuole39.2237 -
N' NATIVEpr-GFP in SD
below threshold17.7989 -
N' TEF2pr-VC and Cyto-VN in SD
below threshold25.341 -
C’ GFP library in SD+DTT

cytosol14.920.87No -
C’ GFP library in SD+H2O2

cytosolN/AN/ANo -
C’ GFP library in Starvation Media

cytosol15.130.88No -
C’ GFP library on the background of Pup2-DaMP

below threshold -
C’ GFP library on the background of CCT mutant

below threshold15.34080.900468No
